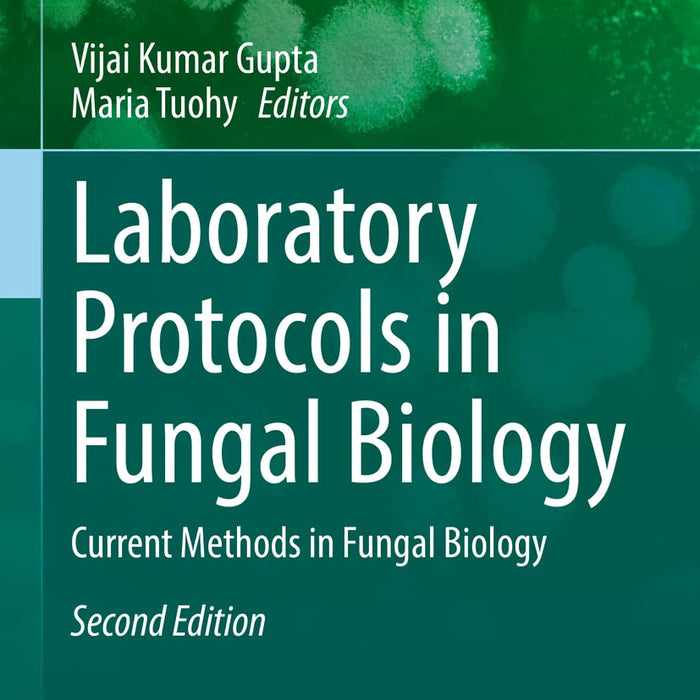
Laboratory Protocols in Fungal Biology: Current Methods in Fungal Biology 2nd Edition Laboratory Protocols in Fungal Biology: Current Methods in Fungal Biology 2nd Edition

Laboratory Protocols in Fungal Biology 2nd Edition by Vijai Kumar Gupta (Editor)
- Publisher: BIOLOGY
- Availability: In Stock
- SKU: 49193
- Number of Pages: 267
Rs.660.00
Rs.895.00
Tags: 2nd edition , advanced fungal protocols , best books , Best Price , Best Selling Books , biotech fungal methods , current fungal research , Current Methods in Fungal Biology , experimental mycology , fungal biology experiments , fungal biology for students , fungal biology protocols , fungal biotechnology , fungal culture techniques , fungal DNA extraction , fungal enzyme studies , fungal genetics , fungal genome protocols , fungal microscopy techniques , fungal molecular biology protocols , fungal pathology research , fungal PCR methods , fungal physiology , fungal research methods , fungal RNA methods , fungal transformation protocols , fungi experimental methods , lab handbook fungal biology , lab manual for fungi , lab protocols mycology , lab techniques for fungi , Laboratory Protocols in Fungal Biology , Maria G Tuohy , methods in fungal biology , microbiology fungal experiments , microbiology lab manual , molecular biology of fungi , mycological studies , mycology lab guide , mycology lab protocols , mycology research , ONLINE BOOKS , Online Bookshop , updated mycology protocols , Vijai Kumar Gupta
📘 Title Name: Laboratory Protocols in Fungal Biology: Current Methods in Fungal Biology (2nd Edition)
✍️ Authors: Vijai Kumar Gupta (Editor), Maria G Tuohy (Editor)
📦 Quality: Black White Pakistan Print
🔹 Introduction:
This volume offers a comprehensive collection of cutting-edge laboratory protocols used in fungal biology. It supports researchers and students in exploring experimental approaches for the study of fungal genetics, physiology, and biotechnology.
🔑 Key Points:
-
Covers updated and validated experimental methods in fungal biology.
-
Useful for research in fungal genetics, molecular biology, and biotechnology.
-
Designed for students, laboratory professionals, and academic researchers.